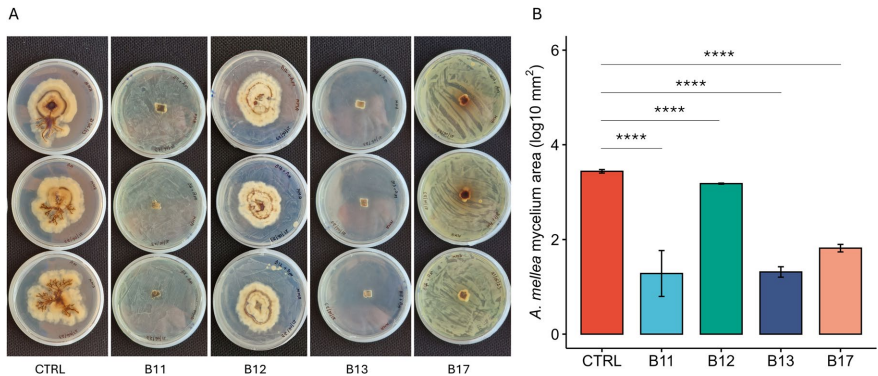

-
生物通官微
陪你抓住生命科技
跳动的脉搏
土壤来源假单胞菌通过微生物组介导效应抑制蜜环菌并促进植物生长
【字体: 大 中 小 】 时间:2025年06月25日 来源:Plant and Soil 3.9
编辑推荐:
本研究针对土传病原体蜜环菌(Armillaria mellea)引起的根腐病防治难题,从土壤微生物组中筛选出4株具有显著抑菌活性的假单胞菌(Pseudomonas spp.),通过全基因组测序发现其含有多种抗真菌代谢物和铁载体合成基因簇。微宇宙实验表明活菌接种可增加橄榄树生物量,同时对根际微生物组影响有限,为开发基于微生物组的生物防治策略提供了新思路。研究发表在《Plant and Soil》杂志。
现代农业面临土传植物病原体管理的重大挑战,其中由蜜环菌(Armillaria mellea)引起的根腐病尤为棘手。这种破坏性真菌病原体能侵染多种作物和树木的根系,导致根系腐烂甚至植株死亡。当前防治方法不仅劳动密集、环境负担重,且效果有限。随着化学防治策略的局限性日益凸显,利用土壤微生物组进行生物防治成为极具前景的替代方案。
意大利雷焦卡拉布里亚地中海大学和克莱姆森大学的研究团队开展了一项创新研究,从土壤微生物组中筛选出能有效抑制蜜环菌并促进植物生长的假单胞菌(Pseudomonas spp.)。研究人员通过大规模筛选获得155株具有抗真菌活性的细菌分离株,最终选定4株假单胞菌(B11、B12、B13和B17)进行深入研究。全基因组测序揭示这些菌株含有编码抗真菌代谢物和铁载体(siderophore)的生物合成基因簇。通过橄榄树(Olea europaea)微宇宙实验证实,活菌接种相比灭活菌能显著增加植物生物量,同时对根部及根际原生微生物组影响有限。研究成果发表在《Plant and Soil》杂志,为开发基于微生物组的可持续农业解决方案提供了重要依据。
研究采用的主要技术方法包括:从不同生境土壤中通过质量筛选法分离抗真菌细菌;采用平板对峙实验评估分离株对蜜环菌的抑制效果;利用牛津纳米孔技术进行全基因组测序和生物信息学分析;通过16S rRNA基因测序(引物515f/806r)分析根际微生物组;在1.5L盆栽系统中进行为期4个月的橄榄树微宇宙实验。
研究结果部分包含以下重要发现:
基因组特征分析
全基因组测序显示,B12和B13分别被鉴定为Pseudomonas spelaei和P. paracarnis,而B11和B17可能代表新种。所有菌株均含有多种次级代谢产物合成基因簇,包括具有抗真菌活性的fengycin、pyrrolnitrin等,以及促进植物生长的铁载体如pyoverdine等。
微生物组影响评估
活菌接种对根际微生物组多样性影响有限,但特定处理如B17增加了根际中Bradyrhizobium等有益菌的相对丰度。图2显示不同处理对根和根际微生物组系统发育多样性的影响。



研究结论指出,从土壤微生物组中筛选的假单胞菌能有效抑制蜜环菌生长,其基因组含有多种抗真菌和促生长相关基因簇。这些菌株在促进植物生长的同时,对原有根际微生物组干扰较小,显示出良好的田间应用潜力。特别值得注意的是,不同菌株可能通过不同机制发挥作用,如B12特异性抑制根状菌索形成,而其他菌株主要抑制菌丝生长。这种功能多样性提示将这些菌株组合成复合菌剂可能获得更稳定的防治效果。
该研究的创新之处在于:首次报道了Pseudomonas spelaei和P. paracarnis作为潜在生物防治剂的应用潜力;阐明了土壤来源微生物在维持微生物组稳定性方面的优势;为开发针对蜜环菌等土传病原体的微生物组管理策略提供了理论依据。未来研究可进一步评估这些菌株在田间条件下的表现,以及与其他农业管理措施的协同效应。这项成果为减少化学农药使用、实现农业可持续发展提供了新的解决方案。
生物通微信公众号
知名企业招聘